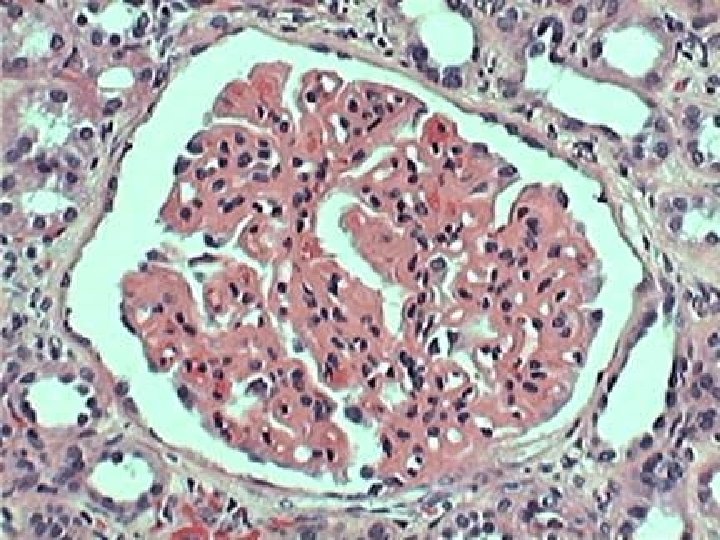

Podzia chorb nerek z elementami patofizjologii Podzia chorb

Podział chorób nerek z elementami patofizjologii

Podział chorób nerek ze względu na: 1 2 Struktury objęte procesem chorobowym m. in. Choroby naczyń (vasculitis) • Choroby kłębuszków nerkowych – kłębuszkowe zapalenia nerek (glomerulopatie) • Choroby pozostałych struktur tkanki nerkowej: –Choroby śródmiąższowe nerek –Wady cewek nerkowych (tubulopatie) wady cewkowe: glikozuria, aminoacidurie, zaburzenia transportu jonów, kwasice cewkowe, nerkopochodna moczówka prosta Pierwotne Kolejność zajęcia tkanki nerkowej przez proces chorobowy ZUM Ostre i Przewlekłe Odmiedniczkowe Zapalenie Nerek Ostre Niebakteryjne Śródmiąższowe Zapalenie Nerek PrzewlekłeŚródmiąższowe Zapalenie Nerek Wtórne 3 Dynamikę przebiegu • Ostre • Przewlekłe • Podostre Nieprawidłowa liczba nerek Wady położenia (dystopia, ektopia) Wady budowy (hipoplazja, dysplazja) Wady przebiegające z powstawaniem torbieli: wielotorbielowatość, torbiele proste, nerka gąbczasta Kamica nerkowa Nowotwory układu moczowego

WYLECZENIE PATOLOGIE PRZEWLEKŁE: (kłębkowe, śródmiąższowe) PATOLOGIE OSTRE: (kłębkowe, śródmiąższ owe) PNN ew. zaostrzenie PNN SNN ONN Leczenie zachowawcze Leczenie nerkozastępcze (Ln) mocznica odwracalna HD, DO, HDF mocznica przewlekła Tx

Choroby śródmiąższu

Uszkodzenie komórek Błona podstawna Zahamowanie przez toksyny naprawy komórek Zahamowanie przez toksyny migracji komórek Hamowanie podziału komórki przez toksyny

dezintegracja struktury komórek działanie toksyny zatkanie światła kanalika nerkowego śmierć komórek apoptoza złuszczenie komórek

wakuolizacja cewek

wakuolizacja cewek

OŚZN

OŚZN_polekowe


OOZN

Infekcyjne. ZN_cewki_Leukocyty i Erytrocyty

POZN

POZN

Choroby kłębuszków nerkowych (glomerulopatie)

PATOGENEZA • Nieprawidłowości wiązania antygenów (Ag) i wyeliminowania ich na drodze fagocytozy i/lub • Nieprawidłowości w funkcjonowaniu układu dopełniacza i/lub • Nieprawidłowa odpowiedź immunologiczna

PATOMECHANIZM

PATOMECHANIZM Krążące wolne Ag gromadzą się w okolicy błony podstawnej, a wytworzone z opóźnieniem przeciwciała (p/c) docierają do kłębuszka i reagują z Ag tworząc złogi kompleksów immunologicznych (IC), Tworzenie p/c przeciwko różnym Ag błony podstawnej kłębuszka z wytworzeniem linijnych złogów, Krążące w surowicy Ag łączą się z p/c tworząc IC, te zaś gromadzą się w kłębuszkach W skład złogów mogą również wchodzić: - składowe dopełniacza - p/c ANCA

zmiany w kłębuszkach: − minimalne

Minimal Change Disease (LM)

Podocyt - obraz prawidłowy (EM)

Minimal Change Disease (EM)

zmiany w kłębuszkach: − minimalne − rozplemowe



zmiany w kłębuszkach: − minimalne − rozplemowe − błoniaste (pogrubienie błony, odkładanie złogów)

Nefropatia błoniasta (EM)

Nefropatia błoniasta (EM)

zmiany w kłębuszkach: − minimalne − rozplemowe − błoniaste − Półksiężyce (proliferacja i nagromadzenie komórek nabłonkowych)





zmiany w kłębuszkach: − minimalne − rozplemowe − błoniaste − półksiężyce − szkliwienie (stwardnienie)

Barwienie typu Massona na tkankę łączną włóknistą

zmiany w kłębuszkach: − minimalne − rozplemowe − błoniaste − półksiężyce − szkliwienie (stwardnienie) − odkładanie złogów

Nefropatia Ig. A Mikroskopia immunofluorescencyjna

Nefropatia błoniasta (IF) Mikroskopia immunofluorescencyjna

zmiany w kłębuszkach: − − − − minimalne rozplemowe błoniasto-rozplemowe półksiężyce szkliwienie (stwardnienie) odkładanie złogów − zwiększenie ilości komórek w kłębuszku

Liczne komórki nie stanowiące struktury kłębuszka

Zmiany w kłębuszkach (ze względu na obraz w bioptacie) • uogólnione • ogniskowe • rozlane • segmentalne Ile procent zajętych kłębuszków? Ile procent zajętych segmentów?
- Slides: 43